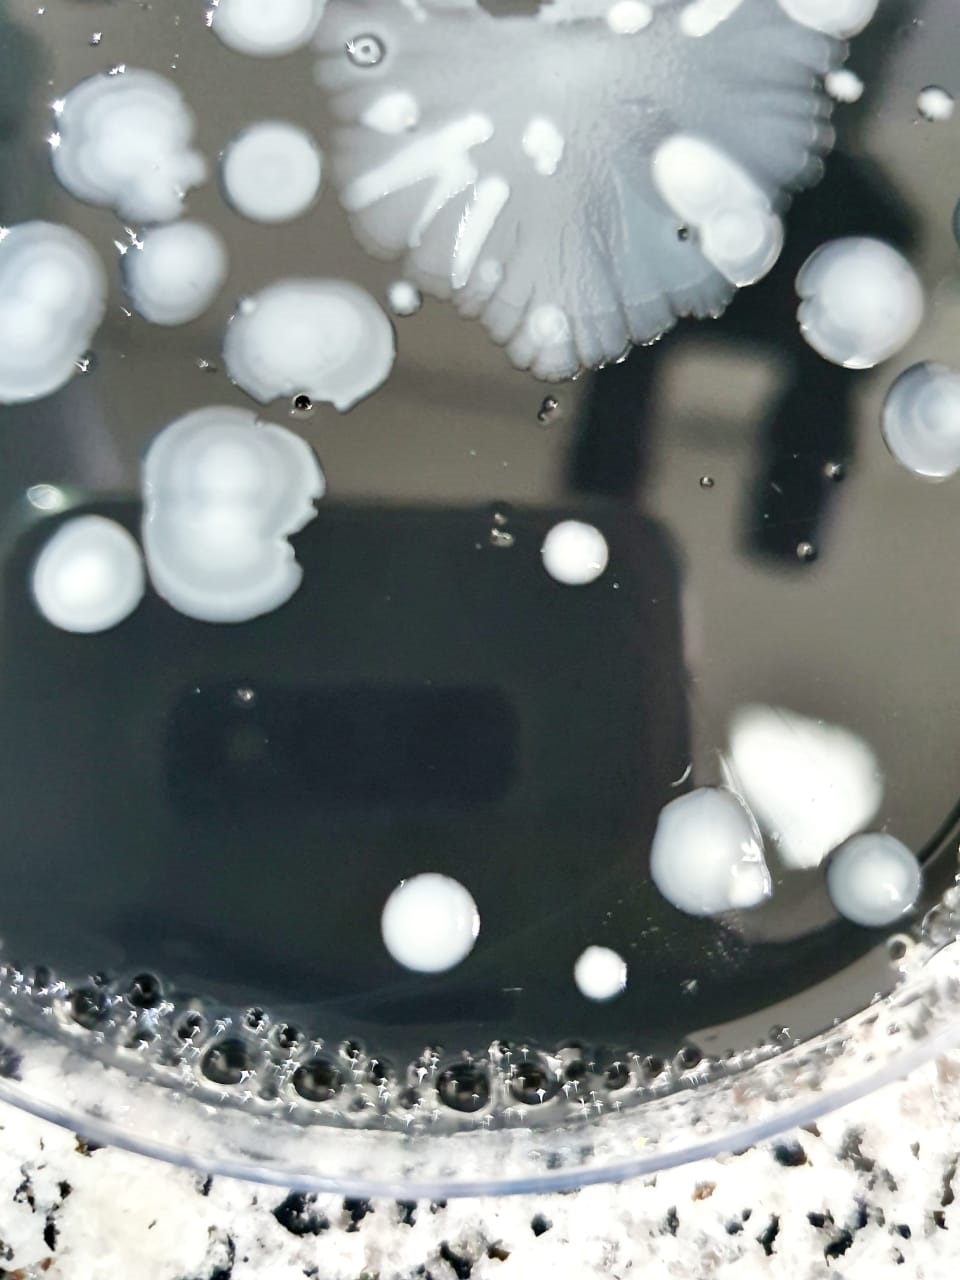

Análise microbiológica em água no ABC
A análise microbiológica em água no ABC é um dos diversos serviços oferecidos pelo laboratório RR Acqua Service. Contamos com uma excelente estrutura para atender todas as demandas por análise microbiológica em água no ABC com muita eficiência e precisão.
Possuímos mais de 15 anos de experiência em serviços de análise microbiológica em água no ABC, análise físico-química e bacteriológica e outras análises de água para consumo humano ou industrial. Dispomos de um sistema de controle de qualidade eficaz, equipamentos modernos e profissionais altamente qualificados para garantir máxima precisão nos resultados de análise microbiológica em água no ABC.
Principais informações sobre a análise microbiológica em água no ABC
A análise microbiológica em água no ABC permite identificar a potabilidade da água através de exames minuciosos. A análise microbiológica em água no ABC pode ser realizada em águas subterrâneas, águas de rios e represas e de outras fontes.
O principal objetivo da análise microbiológica em água no ABC é atestar que a água é apropriada para o consumo humano. Na análise microbiológica em água no ABC é possível avaliar odor, gosto, cor, PH, bactérias heterotróficas, coliformes totais, escherichia coli e outros elementos para identificar a real condição da água.
Com a análise microbiológica em água no ABC é possível detectar micro-organismos que não podem ser vistos a olho nu. A análise microbiológica em água no ABC é de extrema importância para garantir a sua qualidade e a ausência de fatores maléficos a saúde.
O RR Acqua Service é um laboratório que possui um sistema exclusivo que permite aos clientes fazerem o download dos relatórios de análise microbiológica em água no ABC para acessarem sempre que necessário.
O RR Acqua Service faz análise microbiológica em água no ABC
Fale com o RR Acqua Service para obter mais detalhes sobre a análise microbiológica em água no ABC.
Saiba mais sobre Análise microbiológica em água no ABC
Outros assuntos relacionados a Análise microbiológica em água no ABC
Regiões onde a RR ACQUA SERVICE atende através do(s) telefone(s): (011) 44751328 / (011) 49020915
- Bela Vista
- Bixiga
- Cerqueira Cesar
- Morro Dos Ingleses
- ParaÍso
- Bom Retiro
- Luz
- Ponte Grande
- Ponte Pequena
- Brás
- Roosevelt (Cbtu)
- Cambuci
- Vila Deodoro
- Morro da Pólvora
- Várzea do Glicério
- Vila Buarque
- Cerqueira Cesar
- Consolação
- Higienópolis
- Pacaembu
- Aclimação
- Morro da Aclimação
- Bairro do Glicério
- Liberdade
- Paraíso
- Várzea do Glicério
- Canindé
- Pari
- Anhangabaú
- Vila Buarque
- República
- Santa Efigênia
- Barra Funda
- Campos Elíseos
- Luz
- Santa Cecília
- Várzea da Barra Funda
- Anhangabaú
- Parque Dom Pedro 1º
- Mercado
- Sé
- Brasilândia
- Cachoeirinha
- Casa Verde
- Imirim
- Jaçanã
- Jardim São Paulo
- Lauzane Paulista
- Mandaqui
- Santana
- Tremembé
- Tucuruvi
- Vila Guilherme
- Vila Gustavo
- Vila Maria
- Vila Medeiros
- Água Branca
- Bairro do Limão
- Barra Funda
- Alto da Lapa
- Alto de Pinheiros
- Butantã
- Freguesia do Ó
- Jaguaré
- Jaraguá
- Jardim Bonfiglioli
- Lapa
- Pacaembú
- Perdizes
- Perús
- Pinheiros
- Pirituba
- Raposo Tavares
- Rio Pequeno
- São Domingos
- Sumaré
- Vila Leopoldina
- Vila Sonia
- Aeroporto
- Água Funda
- Brooklin
- Campo Belo
- Campo Grande
- Campo Limpo
- Capão Redondo
- Cidade Ademar
- Cidade Dutra
- Cidade Jardim
- Grajaú
- Ibirapuera
- Interlagos
- Ipiranga
- Itaim Bibi
- Jabaquara
- Jardim Ângela
- Jardim América
- Jardim Europa
- Jardim Paulista
- Jardim Paulistano
- Jardim São Luiz
- Jardins
- Jockey Club
- M'Boi Mirim
- Moema
- Morumbi
- Parelheiros
- Pedreira
- Sacomã
- Santo Amaro
- Saúde
- Socorro
- Vila Andrade
- Vila Mariana
- Água Rasa
- Anália Franco
- Aricanduva
- Artur Alvim
- Belém
- Cidade Patriarca
- Cidade Tiradentes
- Engenheiro Goulart
- Ermelino Matarazzo
- Guianazes
- Itaim Paulista
- Itaquera
- Jardim Iguatemi
- José Bonifácio
- Moóca
- Parque do Carmo
- Parque São Lucas
- Parque São Rafael
- Penha
- Ponte Rasa
- São Mateus
- São Miguel Paulista
- Sapopemba
- Tatuapé
- Vila Carrão
- Vila Curuçá
- Vila Esperança
- Vila Formosa
- Vila Matilde
- Vila Prudente
- São Caetano do sul
- São Bernardo do Campo
- Santo André
- Diadema
- Guarulhos
- Ribeirão Pires
- Mauá
- Itapecerica da Serra
- Osasco
- Barueri
- Jandira
- Cotia
- Santana de Parnaíba
- Caierias
- Franco da Rocha
- Taboão da Serra
- Arujá
- Alphaville
Mais Visitados
Análise Artigo 19AAnálise Conama 430Análise de Água MineralAnálise de água no litoralAnálise de água portaria consolidação 05Análise de Água PurificadaAnálise de Àgua SPAnálise de Água NTA 60Análise de Efluente SPAnálise de GeloAnálise de LegionellaAnálise de Legionella em SPAnálise de Poços de MonitoramentoAnálise de PotabilidadeAnálise de potabilidade de poço artesianoAnálise de potabilidade de poço artesiano no Vale do ParaíbaAnálise de Potabilidade SPAnálise físico química da águaAnálise Microbiológica da águaAnálise Microbiológica da água em BHAnálise Microbiológica da água no ABCAnálise microbiológica em águaAnálise Microbiológica no ABCAnálise Microbiológica no Vale do ParaíbaAnálise SS 65Análises Microbiológica de ÁguaColeta por baixa vazão em SPColeta por Low Flow no ParanáEmpresa de análise de águaEmpresa de análise de água em BHEmpresa de análise de água no ABCLaboratório de Análise de água em Minas GeraisLaboratório de Análise de água no litoralLaboratório de Análise de água no Vale do ParaíbaLaboratório de Análise de Água SPLaboratório de Análise de Água No Rio de JaneiroPortaria 5/2017 potabilidade da águaContato
Por favor preencha os campos abaixo para enviar sua mensagem